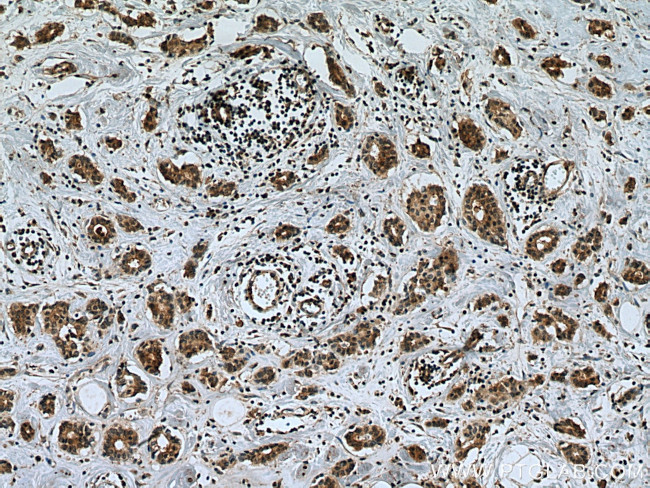
Chk1 Antibody in Immunohistochemistry (Paraffin) (IHC (P))
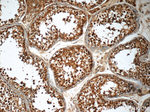
Chk1 Antibody in Immunohistochemistry (Paraffin) (IHC (P))

Search
Proteintech
Chk1 Monoclonal Antibody (3A3A5)
{{$productOrderCtrl.translations['antibody.pdp.commerceCard.promotion.promotions']}}
{{$productOrderCtrl.translations['antibody.pdp.commerceCard.promotion.viewpromo']}}
{{$productOrderCtrl.translations['antibody.pdp.commerceCard.promotion.promocode']}}: {{promo.promoCode}} {{promo.promoTitle}} {{promo.promoDescription}}. {{$productOrderCtrl.translations['antibody.pdp.commerceCard.promotion.learnmore']}}
产品信息
60277-1-IG
种属反应
宿主/亚型
分类
类型
克隆号
抗原
偶联物
形式
浓度
规格
纯化类型
保存液
内含物
保存条件
运输条件
产品详细信息
Immunogen sequence: MKRAVDCPE NIKKEICINK MLNHENVVKF YGHRREGNIQ YLFLEYCSGG ELFDRIEPDI GMPEPDAQRF FHQLMAGVVY LHGIGITHRD IKPENLLLDE RDNLKISDFG LATVFRYNNR ERLLNKMCGT LPYVAPELLK RREFHAEPVD VWSCGIVLTA MLAGELPWDQ PSDSCQEYSD WKEKKTYLNP WKKIDSAPLA LLHKILVENP SARITI (42-256 aa encoded by BC004202)
靶标信息
CHEK1 (CHK1) is a serine/threonine protein kinase involved in preventing replication when DNA integrity is compromised. CHK1 is a key mediator in the DNA damage-induced checkpoint network. CHK1 is an evolutionarily conserved protein kinase that functions to ensure genomic integrity upon genotoxic stress. When the G2 or S checkpoint is abrogated by the inhibition of CHK1, p53-deficient cancer cells undergo mitotic catastrophe and eventually apoptosis, whereas normal cells are still arrested in the G1 phase. Thus, CHK1 inhibitors can preferentially potentiate the efficacy of DNA damaging agents in cancer cells, and Chk1 is an attractive therapeutic target for cancer treatment, especially since approximately 50% of all human cancers are p53-deficient.
仅用于科研。不用于诊断过程。未经明确授权不得转售。
生物信息学
蛋白别名: Cell cycle checkpoint kinase; checkpoint kinase 1 homolog; Checkpoint kinase-1; Checkpoint, S. pombe, homolog of, 1; CHK1 checkpoint homolog; Chk1-S; homolog of Chk1-S; HRD1 Protein; rad27 homolog; Serine/threonine-protein kinase Chk1; Synoviolin; unnamed protein product
基因别名: C85740; CHEK1; CHK1; OZEMA21; rad27
UniProt ID: (Human) O14757, (Rat) Q91ZN7, (Mouse) O35280
Entrez Gene ID: (Human) 1111, (Rat) 140583, (Mouse) 12649